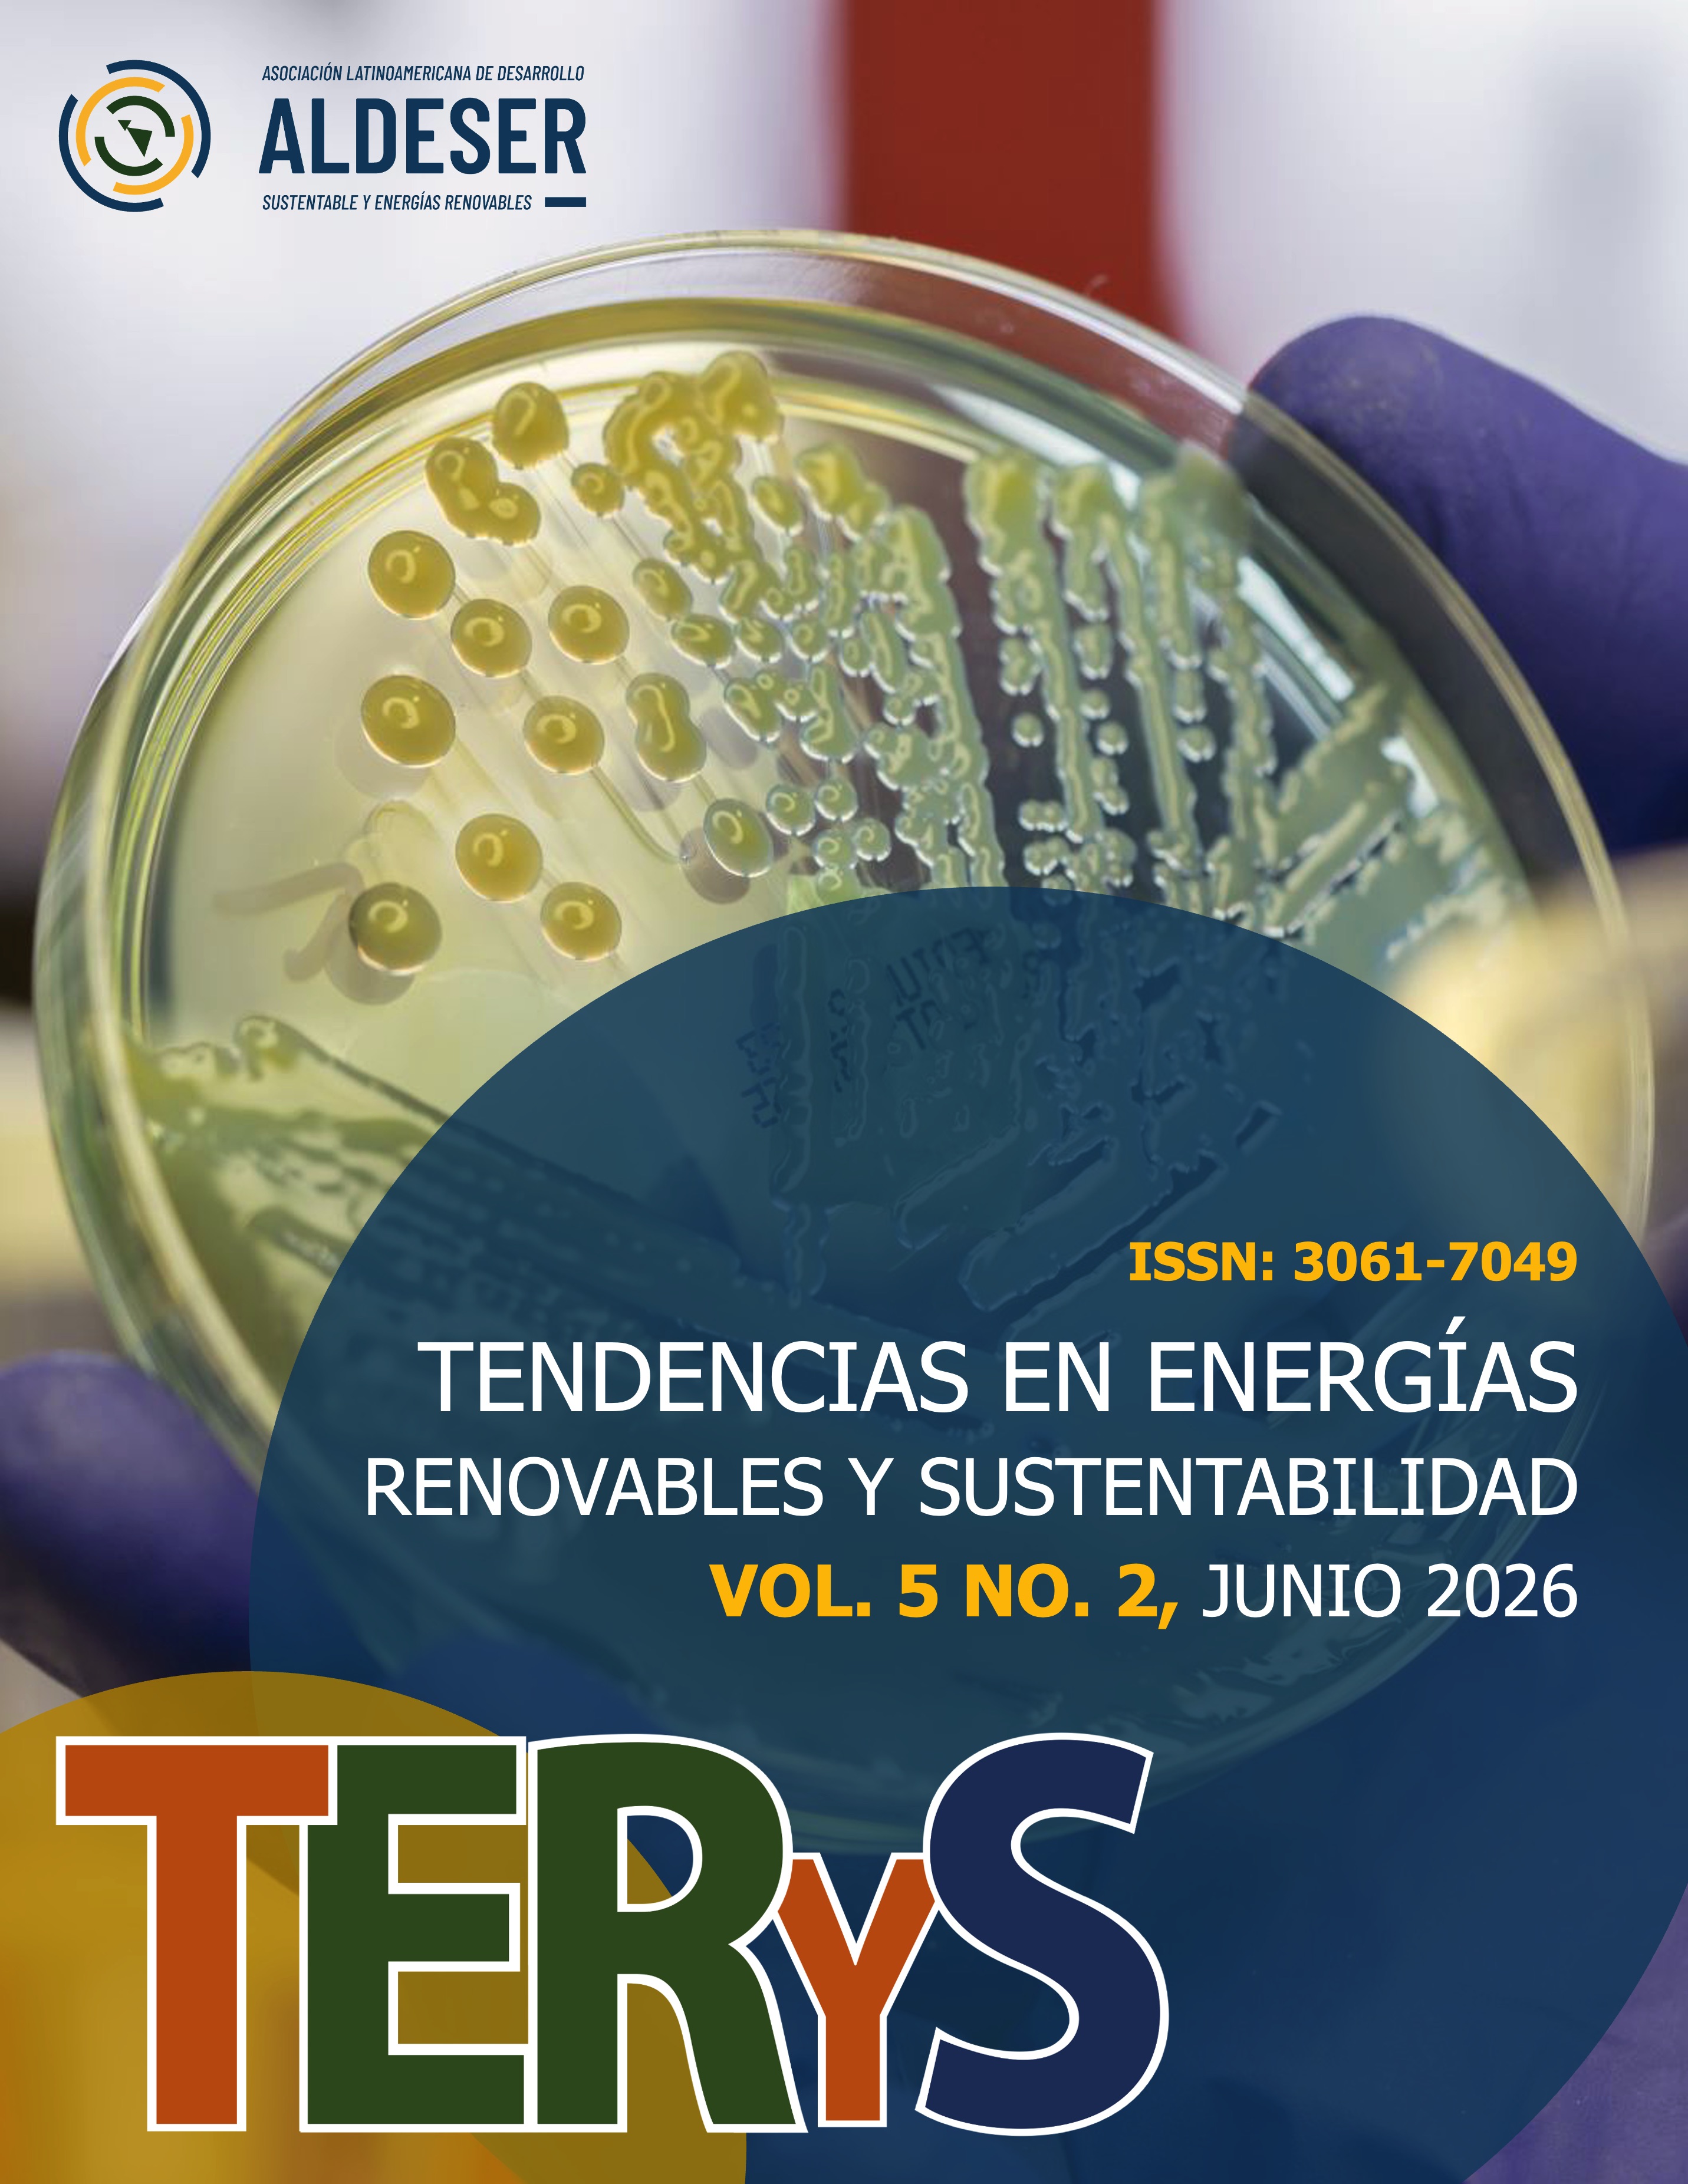
Ver Vol. 5 Núm. 2 (2026)

TERYS Vol. 5 Núm. 2 - Segundo Llamado
Tendencias en Energías Renovables y Sustentabilidad
(Vol. 5 Núm. 2)
Artículos Científicos
Artículos de Divulgación Científica
Tendencias en Energías Renovables y Sustentabilidad es una revista en linea, sin fines de lucro, de Acceso Abierto, revisada por pares, que publica artículos originales de investigación y artículos de divulgación científica, relacionados con las tendencias en energías renovables y sustentabilidad en el entorno Latinoamericano y del resto del mundo.
Esta revista cuenta con el Certificado de Reserva de Derechos de Uso Exclusivo No.: 04-2025-070916283700-102, ISSN: 3061-7049, ambos otorgados por el Instituto Nacional del Derecho de Autor (INDAUTOR, México). La revista TERYS está indexada en Latindex, Google Scholar y CrossRef.
La revista TERYS funciona mediante el modelo de publicación por convocatoria, lo que significa que la presentación de manuscritos a la revista será por medio de una convocatoria con fechas específicas para que la contribución sea subida en la plataforma. Una vez enviado el artículo, pasará por el proceso de evaluación y, una vez aceptado seguirá el proceso de publicación en las fechas programadas correspondientes al número actual de la revista.
Tendencias en Energías Renovables y Sustentabilidad
(Vol. 5 Núm. 2)
Artículos Científicos
Artículos de Divulgación Científica
TENDENCIAS EN ENERGÍAS RENOVABLES Y SUSTENTABILIDAD, Vol. 5 No. 1 - junio 2026, es una publicación anual editada por la Asociación Latinoamericana de Desarrollo Sustentable y Energías Renovables, Av. 20 de Noviembre Oriente No. 327, Col. Centro, Xalapa Veracruz, C.P. 91000, Tel. (272)2372285, www.cidser.org/revista, secretariat@aldeser.org. Editor responsable: Alejandro Alvarado Lassman. Reserva de Derechos al Uso Exclusivo No. 04-2025-070916283700-102, ISSN: 3061-7049, ambos otorgados por el Instituto Nacional del Derecho de Autor. Responsable de la última actualización de este número, Andrea Alvarado Vallejo, Av. 20 de Noviembre Oriente No. 327, Col Centro, Xalapa, Veracruz, C.P. 91000, fecha de última modificación, 16 de febrero de 2026.
 Derechos de autor © D.R. Asociación Latinoamericana de Desarrollo Sustentable y Energías Renovables A. C.,
Derechos de autor © D.R. Asociación Latinoamericana de Desarrollo Sustentable y Energías Renovables A. C.,
except certain content provided by third parties.
Av. 20 de Noviembre Oriente No. 327, Col. Centro, 91000, Xalapa, Veracruz, México
https://aldeser.org/revista.html; secretariat@aldeser.org.
Este sitio utiliza cookies.
